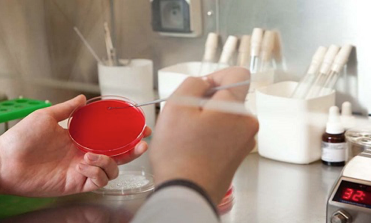
Анализ крови на туберкулез вместо Манту и другие альтернативы проверки реакции для ребенка

Виды альтернативных тестов
Среди наиболее распространенных методик выявления туберкулеза в последнее время получили широкое применение такие, как Диаскинтест, а также — квантифероновый, ПРЦ и Т- СПОТ тесты.
Новые способы обследования естественно вызывают много вопросов. Особенно много их у родителей, которые хотят знать не только, как называется методика, но и что это такое, как проводится, насколько она безопасна.
Диаскинтест
Диаскинтест отличается точностью и практически не вызывает побочных проявлений. Основным его преимуществом перед пробой Манту является возможность проведения после вакцинирования против туберкулеза прививкой БЦЖ. Ведь после этой вакцины почти у всех детей проба Манту дает положительный результат.
Тест на обнаружение инфекции с помощью Диаскинтеста дает возможность выявить только действительно больных туберкулезом детей, потому что прививка БЦЖ не влияет на его результаты.
Этот метод позволяет обнаружить наличие палочки Коха практически со 100 % точностью.

Допускается проведение теста детям в возрасте от 12 месяце и старше, а также взрослым людям.
Критерии оценивания
Проба выполняется подкожно, принцип введения такой же, как и при Манту. Местом для пробы является внутренняя часть предплечья.
Вводится 0.1 мл вакцины, содержащей белковые туберкулезные аллергены, не содержащие возбудителей инфекции (убитых микобактерий). Образовавшаяся папула достигает в диаметре от 7 до 10 мм.
Специфическая реакция организма на введение данной вакцины указывает на наличие/отсутствие заболевания.
- отрицательной является реакция при отсутствии гиперемии и припухлости;
- сомнительной признается проба с гиперемией, но без припухлости;
- на положительную реакцию указывает образование инфильтрата любого диаметра.
Результат Диаскинтеста оценивается через три дня. При этом производится замер образовавшейся папулы. Степень проявления становится показателем носительства инфекции или наличия заболевания, протекающего в активной стадии.
Манту и Диаскинтест можно проводить одновременно в разные руки с целью уточнения диагноза или эффективности лечебного курса.
Квантифероновый тест
Данный тест вместо Манту имеет свои особенности. Основным его отличием от других видов обследования является тот факт, что в детский организм не вводятся никакие компоненты (антигены, микобактерии, туберкулин).
Для проведения теста производится забор крови из вены, которой наполняют пробирку. Затем вводят в нее белки-антигены.
Реакция, полученная в результате взаимодействия компонентов приводит к продуцированию гамма-интерферона. Эти показания являются основанием для заключения о наличии/отсутствии туберкулеза.
Т-СПОТ (Т-SPOT)
Методика Т-СПОТ, зарегистрированная с 2012 года, предусматривает для диагностирования туберкулеза исследование крови пациента в пробирке, как и в Квантифероновом методе.
В эксперименте при сравнении эффективности новой методики диагностирования и традиционной пробы Манту выявлено, что T-SPOT выявил туберкулез у 100 % пациентов старшего возраста и в 78 % — у детей. Тогда как кожная проба определила наличие заболевания у 90 % взрослых и только у 37 % детей.
Суть метода
В ходе тестирования определяется концентрация иммунных клеток, вырабатываемых в качестве ответной реакции на возбудителей инфекции. По их количеству делается вывод о наличии/отсутствии туберкулеза.
В настоящее время данный тест используется в качестве вспомогательного обследования при выявлении ложноположительных результатов в пробах Манту и Перке у детей после вакцинации БЦЖ и ВИЧ-инфицированных пациентов.
Возможные варианты
Кроме перечисленных методов можно сделать и другие пробы. Это:
- Анализ крови – гемотест, который, как и S-SPOT используется в качестве вспомогательного варианта. Его результаты оцениваются по скорости оседания эритроцитов, изменяющейся в значительной степени на фоне инфицирования туберкулезной палочкой.
- ПЦР – чувствительный тест, применяющийся не только для диагностирования туберкулеза, но и других серьезных заболеваний. Серьезный недостаток метода – выявляет не только живых, но и погибших бактерий у больных и выздоравливающих пациентов.
Использование этих методов диагностики не считается полноценной альтернативой пробе Манту. Их применение требует проведения дополнительных уточняющих анализов и проверки более точными способами.
Какой еще анализ можно сдать вместо Манту
Рентгенография информативна, но не делается маленьким детям, так как негативно влияет на растущий организм, может быть назначена в исключительных случаях. Применяется, как способ дополнительной диагностики, при уже обнаруженной тубинфекции с помощью других методик. Рентген показывает патологические очаги в лёгких, подходит только для выявления лёгочной формы туберкулёза. Он дает быстрый результат и одновременно сообщает о наличии или отсутствии других лёгочных отклонений.
Метод ПЦР (полимеразная цепная реакция) считается хорошей альтернативой классической диагностике. Он – высокочувствителен (точность приближается к ста процентам), выявляет любые туберкулёзные формы, безвреден. ПЦР на туберкулез вместо Манту не рекомендуется в послепрививочный период и сразу после противотуберкулёзной терапии. Ввиду того, что в организме ещё присутствуют остатки микобактерий, это влияет на результат, так как фиксируется присутствие палочек Коха, не различая, живые они или нет. Поэтому тест будет положительным.
Квантеферон-тест провоцирует иммунный ответ на тубинфекцию, не имеет противопоказаний, безопасен, но дорого стоит. Положительный результат анализа не всегда говорит о заражении, а отрицательный – не исключает активного заболевания (не выявляет у четверти больных). Применим для выявления латентной формы туберкулёза, после выполнения БЦЖ. При этом методика не делает различий между латентной формой заболевания и активной. Точность выявления тубинфекции – 99%, но также высока и вероятность ошибочного результата.
Проба Суслова – это анализ крови. По специфическим признакам делают вывод о наличии или отсутствии в биоматериале палочки Коха. Выбирается при наличии аллергии и у маленьких детей, безвредна, но имеет существенный недостаток, заключающийся в слабой чувствительности. Основана на применении комплексона и туберкулина, относится к малораспространённым. Болезни легких выявить этим способом проблематично.
Диаскинтест основан на реакции кожи на рекомбинантный туберкулёзный белок. Является усовершенствованной вариацией пробы Манту. Иммунный ответ оценивают через трое суток путём измерения диаметра папулы. К положительным сторонам диагностики относятся высокоточность и простота. Минус – при наличии других инфекционных заболеваний высока вероятность ложного результата и побочной реакции в виде общего недомогания. Такой способ исследования в последние годы очень популярен.

Методика Циля-Нильсена выявляет наличие тубинфекции специфическим анализом слюны. Метод – сложен и включает ряд последовательных химических реакций. Безвреден, применим в отношении детей, аллергиков, при наличии хронических заболеваний. Просто фиксирует наличие туберкулёзной палочки в организме, без выявления степени заболевания, локализации и иных особенностей, почти не распространён.
Анализ мочи, как альтернатива Манту, – недостаточно информативен. При заболевании туберкулёзные микробактерии часто присутствуют в мочевыделительной системе, это говорит о наличии заболевания, но не всегда. Метод подходит для диагностики внелёгочных туберкулёзных форм, безвреден, но на информативность влияют пища, лекарственные препараты, отсутствие стерильности. Наличие палочки Коха в моче определяется одним из трёх способов: бактериоскопия, бактериология, биопроба. Не подходит для выявления тубинфекции в маленьком возрасте у детей.
Фазово-контрастная микроскопия позволяет наблюдать за живыми туберкулёзными микобактериями. Методика предполагает применение специальной аппаратуры. Диагностика безопасна, разрешена даже маленьким детям, но не распространена в нашей стране. Не даёт ложноположительных и ложноотрицательных результатов, позволяет констатировать стадию заболевания и его различные формы.
Люминесцентная микроскопия основана на реакции поражённых зон на ультрафиолетовые лучи. Выявление основано на том, что при таком воздействии туберкулёзные микобактерии начинают светиться. Методика позволяет выявлять тубинфекцию различной локализации, не даёт ошибочных выводов, но не распространена.
Что такое Манту и когда ее проводят
Реакция Манту не относится к плановой вакцинации. Это диагностический способ выявления отношения организма человека к микобактерии туберкулеза. Высокая чувствительность наблюдается или при инфицировании микобактериями либо, если реакция проводится сразу после БЦЖ.
Проба Манту осуществляется при введении под кожу специальной смеси органических компонентов, которые получены из микобактерий (туберкулин). После того, как пуговку поставили, развивается местная аллергическая реакция. Образуется папула, размер и степень красноты которой зависит от «опыта общения» организма ребенка и возбудителей недуга. Малышам запрещено проводить флюорографию и рентген из-за высоких доз облучения (также эти способы не позволяют точно выявить туберкулез), поэтому делается «прививка Манту».
В плановых ситуациях реакция Манту проводится с годовалого возраста (при условии обязательной вакцинации БЦЖ после рождения). Если прививку БЦЖ не сделали, пробу проводят с 6 месяцев.
По итогам ежегодного проведения реакции, на детей заводится личная база результатов исследования. На основе этой информации выявляются контакты детей с зараженными (если они есть). Также данные дают возможность просматривать вираж на реакцию Манту – сравнение размера папул.
До скольки лет делают Манту? Если после ежегодной прививки все показатели в норме – туберкулин в последний раз вводится в подростковом возрасте в школе.
В каком классе пуговка больше не нужна? При исполнении 14 (15 лет) визиты в процедурный кабинет для пробы завершаются (8-9 класс).
Недостатки Манту и когда нужна замена
Впервые детям ставят прививку от туберкулеза в роддоме. Спустя несколько лет организму для повышения устойчивости к заболеванию требуется ревакцинация. Чтобы проверить ребенка на туберкулез, нужна туберкулинодиагностика. Проба Манту для детей важна, она помогает следить за состоянием здоровья и позволяет принять решение о том, нужна ли повторная прививка.

Аналог Манту может понадобиться в случае, если проба на туберкулез ранее дала такие проявления:
- аллергические высыпания;
- покраснение кожи;
- приступы астмы;
- головная боль;
- общее ухудшение состояния;
- повышение температуры;
- чрезмерное нагноение места укола.
Введение туберкулина тяжело сказывается на здоровье, если есть хроническое заболевание, тем более если оно находится в стадии обострения. Помимо туберкулеза, детям введение Манту может угрожать воспалительными процессами, вплоть до сепсиса.
Сегодня медицина предлагает несколько заменителей, которые исключают развитие негативных последствий в таких случаях:
- ребенок ослаблен продолжительной болезнью;
- заболевание сопровождается иммунодефицитом.
Замена привычной пробы устранит риск ложной положительной или ложной отрицательной реакции организма.
Этапы проведения
ПЦР на туберкулез основан на методе термоциклирования и включает в себя следующие этапы:
- Забор биологического материала: крови, мокроты, промывной жидкости бронхов и т.п.
- Для разрушения первоначальных цепочек ДНК микобактерии, материал для анализа держат под воздействием высокой температуры на протяжении нескольких минут (денатурация).
- Снижение температуры для того, чтобы праймеры ДНК соединились с отсоединенной в процессе денатурации цепи ДНК (отжиг).
- Копирование целевых участков ДНК (элонгация).
Чтобы получить необходимое количество копий ДНК микобактерии, осуществляется двадцать пять- тридцать циклов.
Преимущества и недостатки пробы Манту
Пробой Манту называется метод исследования, при котором туберкулин вводится детям под кожу с внутренней стороны предплечья. Туберкулин не является вакциной, не содержит живую или инактивированную микобактерию туберкулеза.
Специфический иммунный ответ детского организма в виде папулы на коже вызывают продукты жизнедеятельности микобактерий. Проверка и оценка результата введения туберкулина производится через 72 часа, размер папулы измеряется прозрачной линейкой.
Согласно федеральным клиническим рекомендациям Российского общества фтизиатров выделяют несколько типов реакции:
- отрицательная реакция – папулы либо нет, либо ее размер менее 1 мм, ребенок никогда не контактировал с микобактериями туберкулеза;
- сомнительная реакция – до 5 мм в диаметре, не имеет диагностического значения;
- положительная реакция – уплотнение от 5 до 16 мм – первичный контакт с палочкой Коха состоялся, но болезнь не развилась;
- гиперергическая реакция – папула более 17 мм, гнойно-некротическое воспаление и увеличение регионарных лимфоузлов свидетельствуют о заболевании туберкулезом, требуется срочное обращение к врачу-фтизиатру.
Реакция Манту не дает представления о распространенности или локализации процесса. Помимо этого, достаточно велико количество ложноположительных результатов:
- при неправильном уходе за местом инъекции;
- при индивидуальной реакции организма малыша на вещества, содержащиеся в пробе, кроме туберкулина;
- при наличии массивной глистной инвазии.
Плюсы и минусы аналогов пробы Манту
Самое главное преимущество Диаскинтеста перед пробой Манту заключается в том, что более современный анализ чувствителен только к возбудителям туберкулеза, тогда как проба Манту может ложноположительно среагировать на туберкулин, который уже был в организме — например, после БЦЖ. К главному недостатку Диаскинтеста относят тот факт, что после него возможны побочные эффекты.
К содержанию
ПЦР
Плюсы метода ПЦР по сравнению с классической пробой Манту:
- специфичность анализа достигает 100%, благодаря чему диагностируются различные формы туберкулеза;
- это безопасный тест, который проводят даже беременным женщинам.
Несмотря на положительные стороны, у данного метода есть и недостатки:
- анализ ПЦР не отличает ДНК погибших возбудителей от живых, то есть недавно излечившийся от туберкулеза человека может показать ложноположительную реакцию;
- метод достаточно дорогой, поскольку это высокотехнологичный процесс.
К содержанию
Квантифероновый тест
Квантифероновый тест также имеет свои плюсы:
- крайне чувствительный и точный метод, даже для ВИЧ-инфицированных и людей с пониженным иммунитетом;
- в 99% случаев успешно показывает результат, даже если туберкулез находится в инкубационном периоде.
Недостатком считают дороговизну теста из-за его технологичности, как и в случае с ПЦР.
К содержанию
T-SPOT
К преимуществам T-SPOT анализа относят следующие факторы:
- это точный (до 98%) и информативный метод;
- безопасность даже для беременных женщин и грудничков;
- не дает ложноположительный результат после БЦЖ.
T-SPOT также достаточно дорогой метод.
Анализы крови и мочи являются вспомогательными методами, позволяющими врачу заподозрить инфекцию. Но полноценными специфическими анализами для диагностики туберкулеза и альтернативой Манту они считаться не могут.
К содержанию
Чем можно заменить Манту
 Несомненно, проба Манту до сих пор остается самым популярным способом тестирования на инфицирование туберкулёзом. Однако с каждым годом появляются всё новые альтернативы Манту. Таким образом, не желая делать Манту или даже просто не имея возможности, люди подбирают достойную альтернативу реакции Манту.
Несомненно, проба Манту до сих пор остается самым популярным способом тестирования на инфицирование туберкулёзом. Однако с каждым годом появляются всё новые альтернативы Манту. Таким образом, не желая делать Манту или даже просто не имея возможности, люди подбирают достойную альтернативу реакции Манту.
Существуют следующие тесты на определение туберкулёза:
- Диаскинтест. Многие слышали о диаскинтесте как об альтернативе Манту, но что это на самом деле, знают лишь некоторые. По сути такая процедура мало чем отличается от Манту, но в диаскинтесте присутствует не бактерия туберкулёза, а только белок. В связи с этим проба Манту часто дает ложные результаты, если обследуемый болен другой инфекцией или недавно контактировал с туберкулёзником. Диаскинтест хоть и надёжнее, но определяет только активный туберкулёз. Процедура проводится путём введения препарата внутрь кожи.
- ПЦР (полимеразная цепная реакция) диагностика. Такая замена Манту показывает свою эффективность в выявлении внелёгочного туберкулёза. Исследуются различные выделения человеческого организма, в которых выделяют ДНК (дезоксирибонуклеиновая кислота), и с помощью этого становится возможным выявление палочки Коха.
- КФТ (квантифероновый тест). Как аналог Манту, этот тест обнаруживает специальный белок, который стимулируется туберкулёзной инфекцией, а значит, свидетельствует о её наличии. Исследованиям подвергается венозная кровь, а сам тест показан людям, которые постоянно общаются с заражёнными или тем, кто недавно контактировал с туберкулёзником.
- T-Spot тест. По принципу действия данный тест похож на предыдущую пробу. Зачастую T-Spot тест назначают людям со сниженным иммунитетом, будь то постоянное состояние или временные проблемы с иммунной системой.
- Анализы крови. Общее исследование крови не столь эффективно как предыдущие тесты (по крайней мере, в плане обнаружения туберкулёза). Такой анализ поможет скорее заподозрить что-то неладное и организовать дополнительные тесты на туберкулёзную инфекцию. Так как анализ крови назначают при многих болезнях, туберкулёз очень часто обнаруживается случайно благодаря смутным результатам.
- Исследование мочи. Так же, как и анализ крови, анализ мочи не показывает точных результатов, но даёт повод врачам заподозрить присутствие болезни. Но такие подозрения появляются, только если очаг инфекции находится рядом с мочеполовой системой, в противном случае исследование мочи не покажет ничего необычного.
Если речь идёт о туберкулёзе легких, то самый надёжный способ диагностики — рентгеновское исследование. Обычно эта процедура проводится среди взрослых ежегодно.
Анализ на основе ПЦР
Эта техника отлично зарекомендовала себя у врачей, и применяется довольно часто, постепенно вытесняя собою другие способы исследований. ПЦР можно проводить не только взрослым, но и детям, так как эта методика не имеет противопоказаний и ограничений по возрасту. Полимеразная реакция позволяет определить туберкулез, локализованный не только в легких, но и в других областях, а также проконтролировать действенность лечения. Пациент должен сдать кровь, которая затем подвергается обработке.
В основе техники – специальная обработка взятого у пациента образца крови, благодаря которой в нем растет число молекул патогенной ДНК.
Определяя затем их тип, можно точно указать, какой именно бактерии/вирусу принадлежит ДНК, и назначить соответствующее лечение. Используется этот анализ в диагностике не только туберкулеза, но и других болезней.
Плюсы ПЦР:
- Диагностика проводится очень быстро, результат может быть получен уже через 4 часа.
- Она определяет туберкулез любых локализаций.
- Тестирование очень точное, поскольку определяет конкретного возбудителя.
Даже единственной микобактерии будет достаточно для того, чтобы обнаружить туберкулез методом ПЦР – ни Манту, ни анализ крови не имеют такого достоинства. Также, помимо точности выявления, ПЦР показывает примерный уровень размножения микобактерий в организме человека. ПЦР назначают и при подозрениях на легочный туберкулез, и на внелегочные его разновидности.
Пригоден этот метод и для экспресс-выявления болезни. ПЦР способна быстро определить наличие заболевания и его источник. Таким образом, данный способ диагностики способен полноценно заменить другие методы во всех аспектах, показывая при этом более точные и надежные результаты.
ПЦР диагностику применяют не только для выявления самой болезни, но и для предупреждения вероятных рецидивов болезни. В среднем такие рецидивы происходят спустя год после излечения и окончания реабилитации, именно в это время наиболее велик риск заразиться повторно. Чтобы понять, было ли повторное инфицирование, часто применяют ПЦР-диагностику, хотя выбор окончательного способа тестирования остается за врачом. Выбор этот будет зависеть от множества факторов – состояния испытуемого, времени, когда проводится диагностика, возраста пациента и многого другого. Например, в школах ИФА проводят редко, отдавая предпочтение Манту, а для взрослых методы ИФА и ПЦР назначаются гораздо чаще. Практически всегда эти анализы проводят тем, кто уже переболел раньше или находится на текущий момент под врачебным наблюдением.
Каждый год по достижению ребенком годовалого возраста необходимо проводить пробу Манту – диагностическую процедуру, позволяющую выявить наличие в организме возбудителя такого опасного заболевания как туберкулез. Несмотря на повсеместность использования данного метода в дошкольных и школьных учебных учреждениях, вокруг него множество споров. Некоторые утверждают, что такая проба опасная для организма ребенка из-за особенностей вводимого под кожу состава и при этом недостоверна, что приводит к ненужной постановке большого числа детей на учет в диспансер. Кроме прочего, проба очень часто вызывает аллергию, что также негативно влияет на полученный результат.
Проба Манту является добровольной процедурой, родители могут от нее отказаться, если считают такой шаг целесообразным. Но оставлять ребенка без туберкулиновой диагностики попросту опасно, поэтому стоит рассмотреть другие способы контроля заболевания.
На сегодняшний день их несколько, и каждый обладает своими плюсами и минусами.
Какой размер Манту считается нормой у детей
Реакция Манту является диагностическим тестом и входит в комплекс мероприятий, которые проводятся с целью выявления тубинфицирования.
Пробу проводят перед ревакцинацией и вакцинацией БЦЖ, если прививку не сделали в роддоме, а возраст уже более 2 месяцев. Массовой диагностике подлежат дети и подростки от 1 года до 17 лет.
При ежегодном проведении реакции Манту размеры нормы у детей разных возрастов отличаются.
Внешний вид папулы Манту
Мероприятия по туберкулинодиагностике регламентированы определенными нормами и приказами. Проба делается только после осмотра педиатра с оценкой состояния здоровья ребенка, после болезни (нетяжелых ОРЗ, ОРВИ) должно пройти 2-3 недели.
Тест на туберкулез — это внутрикожная инъекция на средней трети предплечья с 2 ТЕ (туберкулиновыми единицами) аллергена.
При проведении пробы у ребенка на коже образуется папула («лимонная корочка» или «пуговка») диаметром около 8 мм. Через 20-30 минут она сглаживается.
Можно оценить результат по таблице:
| Отрицательнаяреакция | Отсутствие папулы и покраснения либо уколочная реакция (инфильтрат от 0 до 1 мм) |
| Сомнительнаяреакция | Инфильтрат 2-4 мм либо гиперемия (независимо от размера). |
| Положительнаяреакция | Инфильтрат 5-16 мм (слабоположительная — до 9 мм, средневыраженная — до 14 мм, выраженная — до 16 мм) |
| Гиперергическаяреакция (гиперпроба) | Инфильтрат 17 мм и выше; везикуло-некротическая проба |
Везикуло-некротическая реакция проявляется омертвением клеток кожи; вокруг инфильтрата образуются пузырьки, гнойнички или дочерние отсевы. Возможно развитие лимфангоита или регионарного лимфаденита с увеличением локтевых или подмышечных лимфоузлов. Независимо от размеров инфильтрата, такая реакция считается гиперергической.
Какой должна быть норма размера реакции Манту у детей разных возрастов
Норма Манту у детей по годам может меняться в зависимости от интервала с прививкой БЦЖ и размеров сформировавшегося рубчика. Результат диагностического исследования зависит и от индивидуальных особенностей детского организма.
Тест будет положительным, если иммунная система ребенка сталкивалась с туберкулезным возбудителем. Это может случиться после введения вакцины БЦЖ, которая содержит лабораторную культуру микобактерий либо при контакте с носителем туберкулезных микобактерий.
Норма Манту у детей 1 года
После вакцинации у ребенка развивается невосприимчивость (иммунитет) к туберкулезу. Иммунная система активно реагирует на внедрение туберкулезного аллергена, и в 1 год проба чаще бывает положительной — покраснение и папула до 10-11 мм.
Норма Манту у детей в возрасте от 2 до 6 лет
После 2 лет реакция постепенно уменьшается в связи с ростом резистентности организма. Размеры инфильтрата варьируются в пределах 5-8 мм или появляется только гиперемия.
Норма для детей старше 6 лет
Иммунологическая поствакцинальная реакция к 6 годам угасает и результаты становятся чаще отрицательными или сомнительными. Педиатры решают в соответствии с результатами диагностики Манту, когда можно проводить ревакцинацию БЦЖ.
Когда необходима консультация врача
К фтизиатру (врачу тубдиспансера) направляют ребенка:
- с усиливающейся чувствительностью к туберкулину;
- с подозрением на вираж тубпроб;
- при наличии гиперпробы.
Виражом называют впервые положительную пробу после отрицательной или сомнительной.
Специалист решит вопрос о том, с чем связана положительная проба — с наличием микобактерий туберкулеза или аллергическими свойствами организма. Врач обязательно учитывает интенсивность проявления реакции, наличие прививок БЦЖ, размер поствакцинальных рубчиков, вероятность контакта с больным туберкулезом и клинические симптомы болезни.
При необходимости врач назначит лечение и даст рекомендации по организации режима занятий и сбалансированности питания
Для укрепления защитных сил организма важно, ведете ли вы здоровый образ жизни, достаточно ли употребляете мяса, рыбы, молочных продуктов, как часто вы едите овощи и фрукты
Осмотры у фтизиатра проводятся несколько раз в год; вообще диспансерное наблюдение ведется до снятия с учета.

















































































































